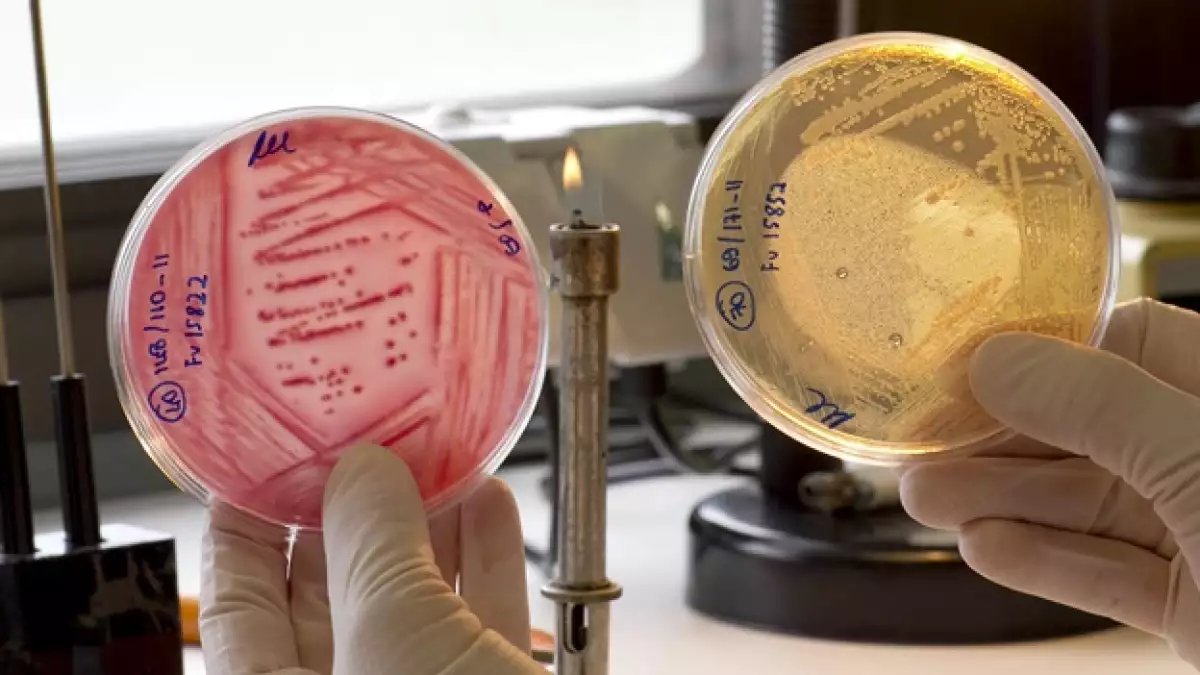

Cuatro personas mueren por 'E. coli' en Alemania; ya son 35 las víctimas
Cuatro personas más murieron en Alemania a causa del brote de E. coli, lo que aumenta el número de víctimas por esta bacteria a 35, informaron funcionarios de salud de Alemania.
Las víctimas fallecieron en ese país, excepto una mujer que murió en Suecia pero había visitado Alemania poco antes, de acuerdo con la Organización Mundial de la Salud (OMS) y el Centro Europeo para la Prevención y Control de Enfermedades (ECDC, por sus siglas en inglés).
El número de infectados con E. coli era de 3,256 personas hasta el domingo, según el ECDC. De ellos, 812 sufren una forma severa de la enfermedad intestinal.
Todos excepto cinco personas habían viajado a Alemania durante el periodo de incubación de la infección, que usualmente es de tres o cuatro días antes de que la enfermedad se manifieste, según la OMS.
Las autoridades alemanas indicaron que algunos alimentos que incluían germinados de soya y otros vegetales producidos en Baja Sajonia, en Alemania, parecen ser la fuente de la infección. Las autoridades alemanas de salud ordenaron sacar del mercado todas las cosechas provenientes de ese productor, según la ECDC.
El ministro de agricultura en Baja Sajonia dijo el domingo que todavía no está claro cómo se contaminaron los brotes de la granja con la bacteria.
"No está claro si el empleado llevó la bacteria a la compañía o si ésta llegó en las semillas que luego contaminaron al trabajador", según un comunicado del ministerio.
"Entender esto es importante para que podamos crear sistemas tempranos de alerta para prevenir este tipo de brotes en el futuro", según el comunicado.
Investigadores encontraron que los germinados de soya eran la causa del brote al notar que 17 de los enfermos habían mostrado síntomas luego de comer en el mismo restaurante, explicó Reinhard Burger, presidente del Instituto Robert Kocho, responsable del Control y Prevención de Enfermedades en Alemania. Sólo los que habían comido alimentos con germinado de soya se enfermaron, relató.
Granjeros en España, Francia, Holanda y Bélgica buscan una compensación por las pérdidas. La Comisión Europea ha propuesto que la Unión Europea pague cerca de 300 millones de euros, pero España exige 600 en pérdidas. Al principio de la crisis, Alemania señaló a España como posible origen del brote .